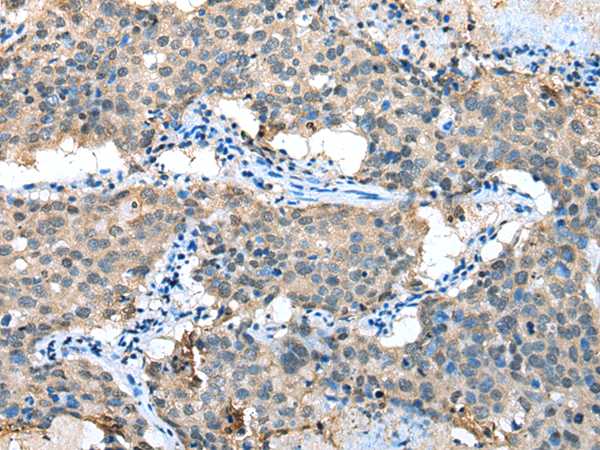
一抗

|
Background: |
This gene encodes a cytosolic enzyme that is responsible for the metabolism of cysteine conjugates of certain halogenated alkenes and alkanes. This metabolism can form reactive metabolites leading to nephrotoxicity and neurotoxicity. Increased levels of this enzyme have been linked to schizophrenia. Multiple transcript variants that encode different isoforms have been identified for this gene. [provided by RefSeq, Jul 2008] |
|
Applications: |
ELISA, WB, IHC |
|
Name of antibody: |
KYAT1 |
|
Immunogen: |
Fusion protein of human KYAT1 |
|
Full name: |
kynurenine aminotransferase 1 |
|
Synonyms: |
GTK; KAT1; KATI; CCBL1 |
|
SwissProt: |
Q16773 |
|
IHC positive control: |
Human lung cancer |
|
IHC Recommend dilution: |
25-100 |
|
WB Predicted band size: |
48 kDa |
|
WB Positive control: |
Rat kidney tissue |
|
WB Recommended dilution: |
500-2000 |


 購物車
購物車 幫助
幫助
 021-54845833/15800441009
021-54845833/15800441009